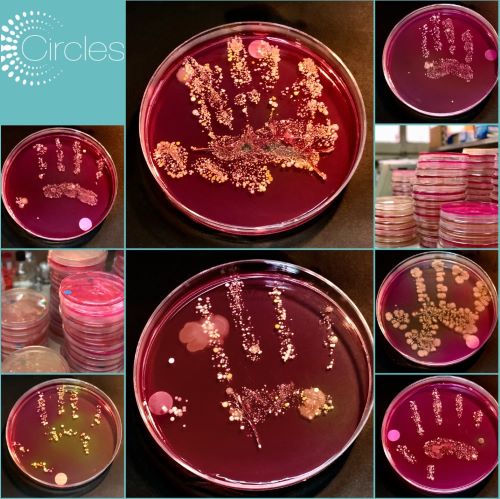

November 2019
Second CIRCLES newsletter is out!
Read our second newsletter: CIRCLES: 2019 World Microbiome Day, EU R&I Days and much [...]
1 year of CIRCLES: Unraveling the mystery of microbiomes
By Daniëlle Schweitzer – Hague Corporate Affairs One year ago, a group of [...]
October 2019
Fishy microbes and their importance for animal life
By Arne Holst-Jensen – Norwegian Veterinary Institute Long before the first human civilisation developed, [...]
CIRCLES at Unijunior Bologna
October 19th, 2019 - CIRCLES at UNIJUNOR, Bologna UNIJUNIOR, 19 Ottobre 2019 UNIJUNIOR [...]
Margarine and microbiome: a topic worth spreading
By Silvia Alunni – Hague Corporate Affairs Fats have been under the spotlight for [...]
September 2019
CIRCLES at the R&I days 2019
This year, on 24-26 of September, was the first edition of the European Research [...]